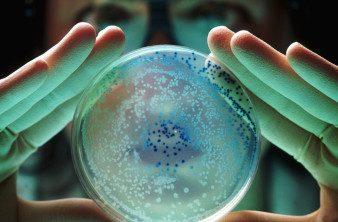
Alt text

EDITOR OF TECHGEAR
Elissavet Karypidou
Ανέκαθεν μου κινούσαν το ενδιαφέρον οι συναρπαστικές ιστορίες που κρύβονται πίσω από την επιστήμη της ζωής, από το DNA μας μέχρι τις μεγάλες ιατρικές ανακαλύψεις. Παράλληλα, βυθίζομαι στον κόσμο του σινεμά και των τηλεοπτικών σειρών! Και τι καλύτερο από το να μοιράζεσαι αυτές τις ανακαλύψεις και εμπειρίες;